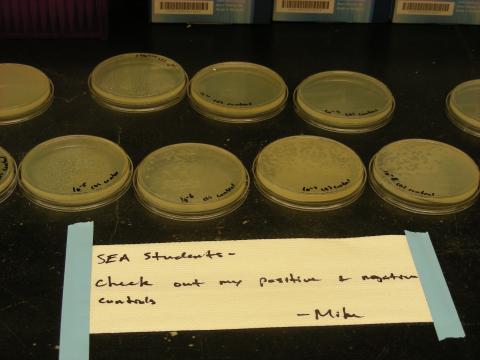
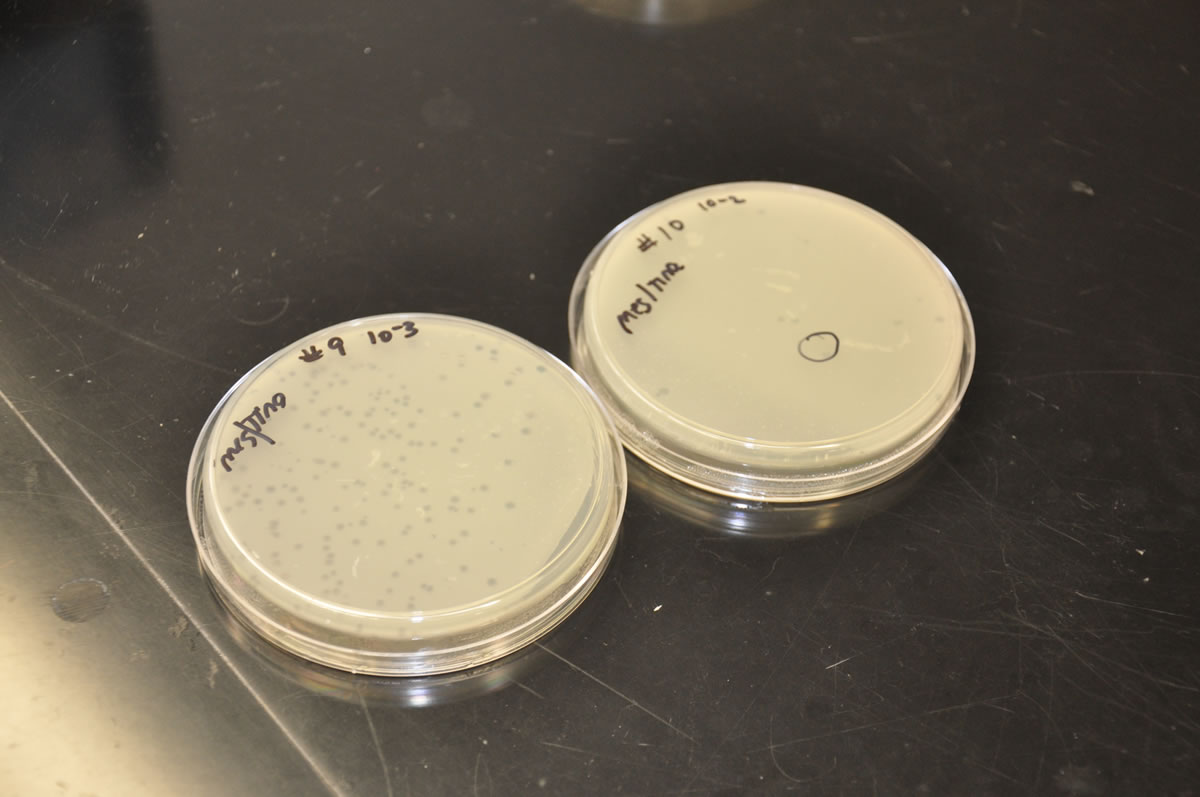
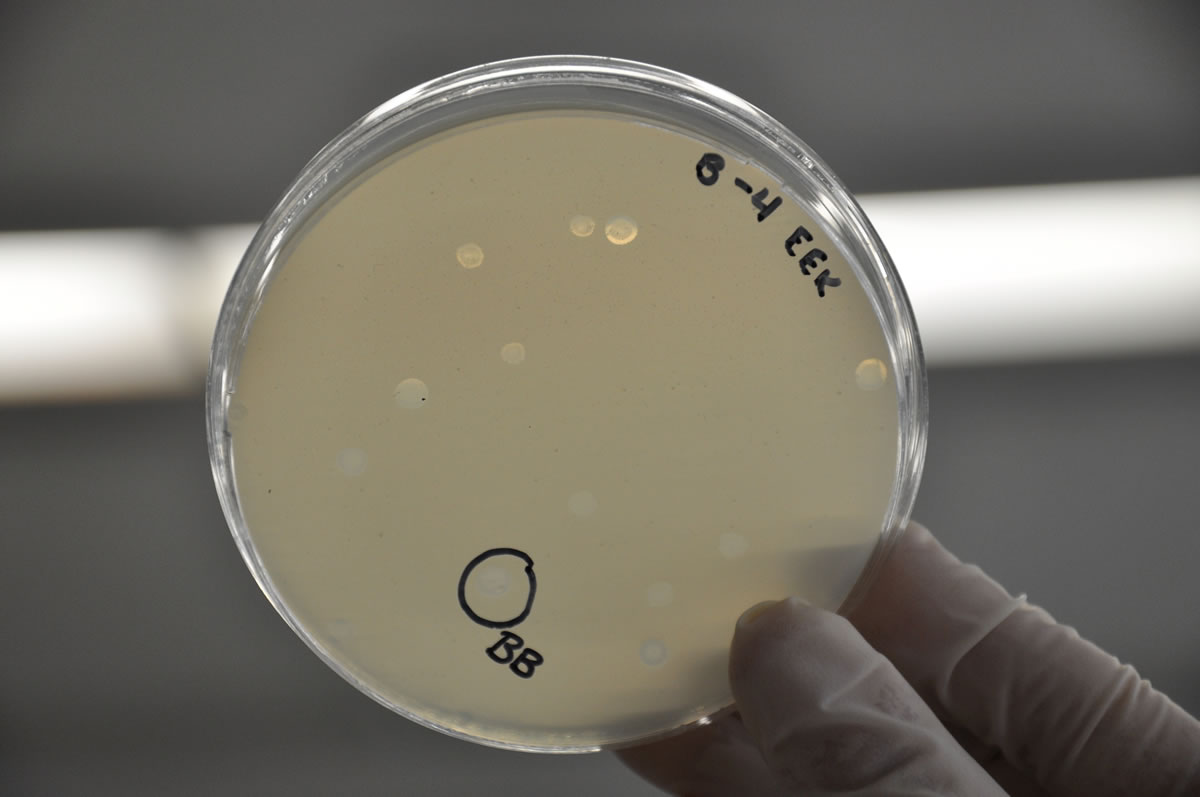

2019 Baby Pictures

2018 Baby Pictures

2010-2011 Question of Week Winners









































Tame 2009- Purifying Dirt to Isolate Phages

SEA 2009-2010 Baby Pictures
.jpg)
















Lab Meetings 2009-2010- Putting our Heads Together










June 2010 SEA Symposium at Janelia Farm















Fall 2009 HHMI Mother Shark Comes to Visit




Dissect 2010 Visualizing Phages Electron Microscope















Dissect 2009 Visualizing Phages Electron Microscope






Capture 2010






































Capture 200 Searching for our Phages

















Bench Research 2010-2011

Bench Research 2009-2010























SEA Poster Sessions 2009-2010






Question of Week Winners 2009 2010













Lehigh in the SEA-phages 2009-2010
















